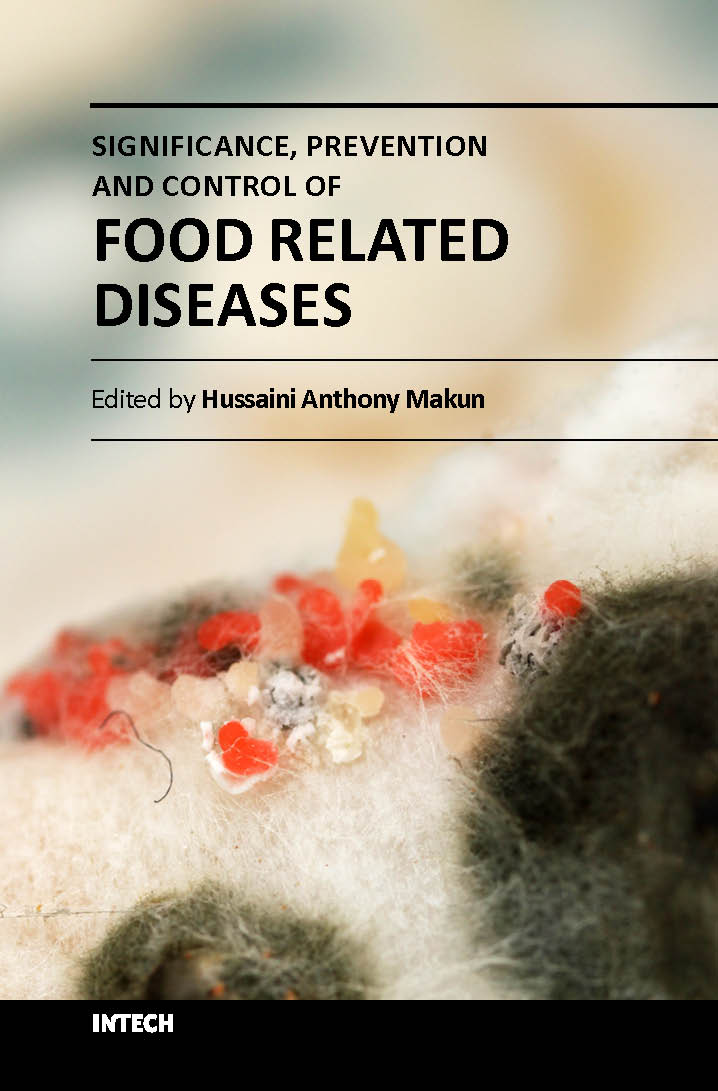
Significance prevention and control of food related diseases (hb 2017)

Food-borne diseases are major causes of morbidity and mortality in the world. It is estimated that about 2.2 million people die yearly due to food and water contamination. Food safety and consequently food security are therefore of immense importance to public health, international trade and world economy. This book, which has 10 chapters, provides information on the incidence, health implications and effective prevention and control strategies of food-related diseases. The book will be useful to undergraduate and postgraduate students, educators and researchers in the fields of life sciences, medicine, agriculture, food science and technology, trade and economics. Policy makers and food regulatory officers will also find it useful in the course of their duties.
| Specifications |
Descriptions |
| ISBN |
9789535122777 |
| Published Year |
2017 |
| Binding |
Hardcover |
| Subject |
Agriculture |
| Pages |
314 |
| Weight |
0.4 (In Kg) |
| Readership |
NA |